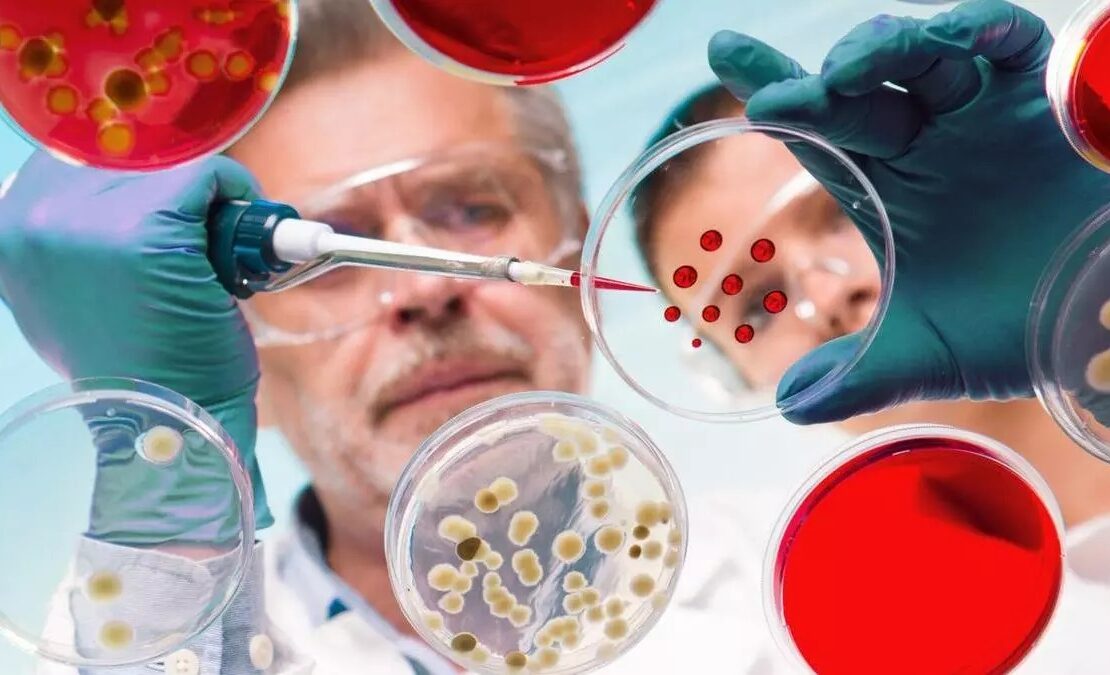

Las infecciones resistentes a los antibióticos han emergido como un desafío crítico para el sistema de salud global. Esta preocupación ha ganado terreno en la agenda...
Categoría: Noticias
Aumento de peajes en rutas nacionales: Nuevas tarifas vigentes desde hoy
El gobierno nacional ha implementado un aumento en las tarifas de peaje, correspondiente al tercer ajuste en lo que va del año. Esta decisión, tomada por...
Gremios universitarios anuncian paro y suspensión del inicio del segundo cuatrimestre por demandas salariales
El Frente Sindical de Universidades Nacionales ha decidido implementar un plan de lucha que incluye un paro de 72 horas, programado para los días 12, 13...
Julián Ercolini ordena restricción perimetral y medidas de protección contra Alberto Fernández tras denuncia de Fabiola Yáñez por violencia
La justicia argentina ha impuesto una restricción de acercamiento perimetral contra el expresidente Alberto Fernández, luego de que la ex primera dama, Fabiola Yáñez, lo denunciara...